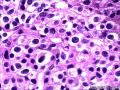

| 图片: | |
|---|---|
| 名称: | |
| 描述: | |
- 左侧额叶占位
| 性别 | 女 | 年龄 | 62 | 临床诊断 | 转移癌? |
|---|---|---|---|---|---|
| 一般病史 | 头疼,行走不稳2天发现左侧额叶占位。 | ||||
| 标本名称 | 左侧额叶肿物 | ||||
| 大体所见 | 灰褐色及灰白色不整形组织2块,大小:4.3×4×3.8cm,切面大部分灰白色,局灶灰褐色,坏死样,质软。 | ||||
标签:
-
本帖最后由 雅马哈 于 2013-04-16 20:17:37 编辑
×参考诊断